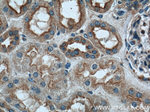
CLTC Antibody in Immunohistochemistry (Paraffin) (IHC (P))

Search
Proteintech
CLTC Polyclonal Antibody
{{$productOrderCtrl.translations['antibody.pdp.commerceCard.promotion.promotions']}}
{{$productOrderCtrl.translations['antibody.pdp.commerceCard.promotion.viewpromo']}}
{{$productOrderCtrl.translations['antibody.pdp.commerceCard.promotion.promocode']}}: {{promo.promoCode}} {{promo.promoTitle}} {{promo.promoDescription}}. {{$productOrderCtrl.translations['antibody.pdp.commerceCard.promotion.learnmore']}}
产品信息
26523-1-AP
种属反应
宿主/亚型
分类
类型
抗原
偶联物
形式
浓度
规格
纯化类型
保存液
内含物
保存条件
运输条件
产品详细信息
Immunogen sequence: MAQILPIRF QEHLQLQNLG INPANIGFST LTMESDKFIC IREKVGEQAQ VVIIDMNDPS NPIRRPISAD SAIMNPASKV IALKAGKTLQ IFNIEMKSKM KAHTMTDDVT FWKWISLNTV ALVTDNAVYH WSMEGESQPV KMFDRHSSLA GCQIINYRTD AKQKWLLLTG ISAQQNRVVG AMQLYSVDRK VSQPIEGHAA SFAQFKMEGN AEESTLFCFA VRGQAGGKLH IIEVGTPPTG NQPFPKKAVD VFFPPEAQND FPVAMQISEK HDVVFLITKY GYIHLYDLET GTCIYMNRIS GETIFVTAPH EATAGIIGVN RKGQVLSVCV EEENIIPYIT NVLQNPDLAL RM (1-351 aa encoded by BC054489)
靶标信息
Clathrin is the major protein of the polyhedral coat of coated pits and vesicles. Two different adapter protein complexes link the clathrin lattice either to the plasma membrane or to the trans-Golgi network.
仅用于科研。不用于诊断过程。未经明确授权不得转售。
生物信息学
蛋白别名: Clathrin heavy chain 1; Clathrin heavy chain 2; Clathrin heavy chain on chromosome 17; Clathrin heavy chain on chromosome 22; clathrin, heavy polypeptide (Hc); Clathrin, heavy polypeptide D; clathrin, heavy polypeptide-like 1; clathrin, heavy polypeptide-like 2; CLH-17; CLH-22; KIAA0034; unnamed protein product
基因别名: 3110065L21Rik; CHC; CHC17; CHC22; CLH-17; CLH17; CLH22; CLTC; CLTCL; CLTCL1; CLTCL2; CLTD; Hc; KIAA0034; MRD56; R74732
UniProt ID: (Human) Q00610, (Human) P53675, (Rat) P11442, (Mouse) Q68FD5
Entrez Gene ID: (Human) 1213, (Pig) 100271929, (Human) 8218, (Rat) 54241, (Mouse) 67300